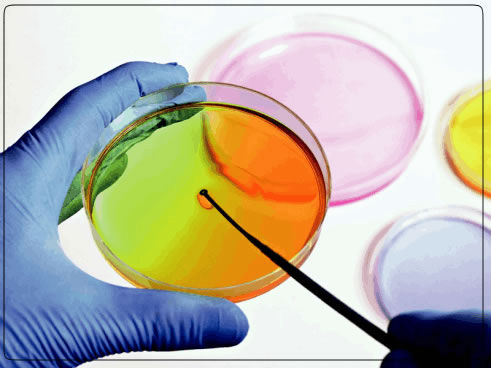

Buenos prácticas asesoramiento externo
Asesoramiento, desarrollo e implementación de Buenas Prácticas de Manufactura (BPM) y Buenas Prácticas Agrícolas (BPA)
Desarrollo de manuales de calidad, buenas prácticas de manufactura, HACCP, trazabilidad, Recall y check list.
Desarrollo de documentos para los Pre – requisitos de BPM: Manejo integral de plagas y Procedimientos Estandarizados de Saneamiento
Elaboración de fichas técnicas del producto y registros de producción
Asesoramiento para diseño higiénico y sanitario de establecimientos elaboradores de alimentos.
Desarrollo de protocolos para la estandarización de los procedimientos
Análisis Microbiológicos
Análisis microbiológicos en nuestros laboratoriosm propios y oficiales.
Análisis microbiológicos ambientales, de superficies
y de agua.

Mantenimiento
Contamos con un equipo técnico que controla bimestralmente los equipos instalados y los resultados obtenidos.
Mantenemos constante contacto con nuestros clientes con control de verificación de los equipos y registro de las actividades en los mismos.
Asistencia técnica
El equipo técnico de Eco03® esta a su disposición para cualquier consulta técnica que nuestros clientes necesiten.
Su consulta es importante para nosotros.
Consultas técnicas por whatsapp
11.5632.5501
Consultas técnicas por mail
calidad@eco03.com.ar
